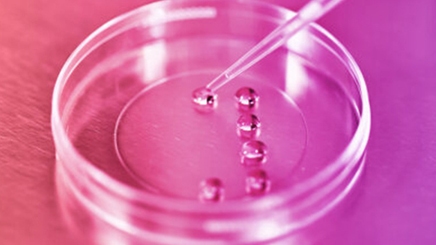
petri-dish512x288

Non-invasive preimplantation genetic testing for embryology
Bill Venier, M.Sc, TS, ELD (ABB) and Deb Venier, MS, TS, of World Embryology Skills and Training (W.E.S.T.) draw from their many years of experience in the embryology lab to discuss their perspective on non-invasive PGT-A. They candidly answer many frequently asked questions, talk about what the future of PGT-A may look like, and share some best practices to help get reliable non-invasive PGT-A results. Their video walkthrough of the denudation process at the 10-minute mark is particularly helpful!
For research use only. Not for use in diagnostic procedures.
To view the full content please answer a few questions




























